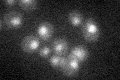
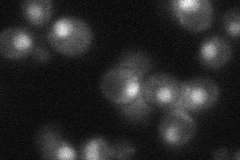
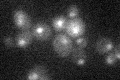

View description
Catalytic (alpha) subunit of C-terminal domain kinase I (CTDK-I), which phosphorylates both RNA pol II subunit Rpo21p to affect transcription and pre-mRNA 3' end processing, and ribosomal protein Rps2p to increase translational fidelity
Localization:
Intensity:
Fold change:
Significance:
-
C’ GFP library in SD
nucleus25.46 -
N' NOP1pr-GFP in SD

nucleus49.4904 -
N' TEF2pr-mCherry in SD

nucleus29.7341 -
N' NATIVEpr-GFP in SD
nucleus33.9723 -
N' TEF2pr-VC and Cyto-VN in SD

#N/A0 -
C’ GFP library in SD+DTT

nucleus27.321.07No -
C’ GFP library in SD+H2O2

nucleus21.550.84No -
C’ GFP library in Starvation Media
nucleus18.430.72Yes -
C’ GFP library on the background of Pup2-DaMP

nucleus -
C’ GFP library on the background of CCT mutant

nucleus28.91771.13535No
